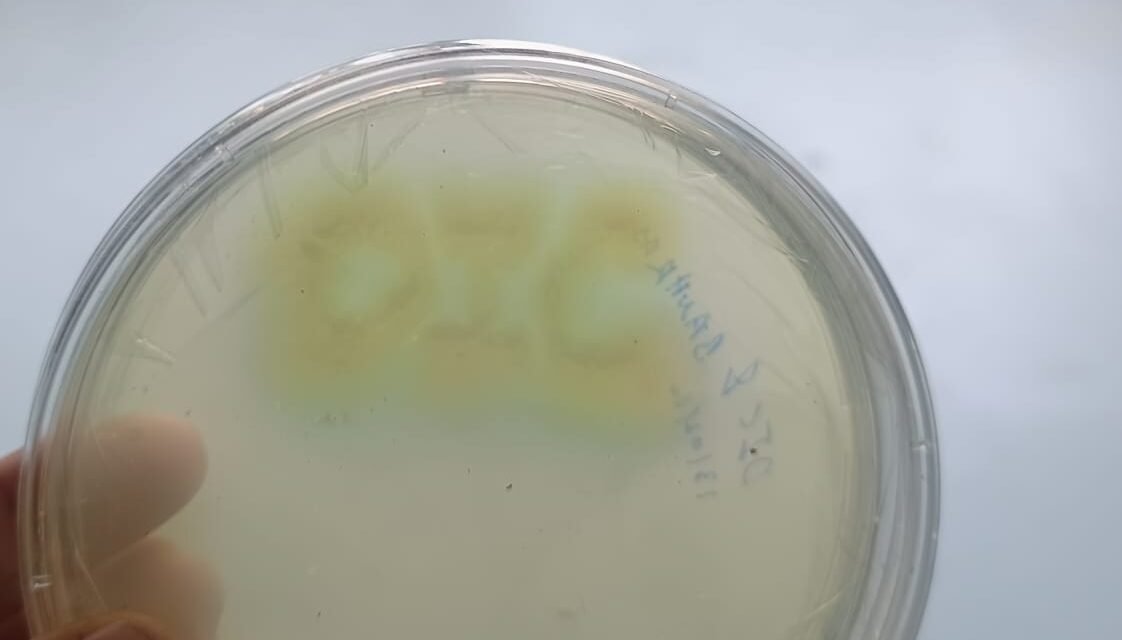
Bacterial Art

Introduction :
Bacterial art is a form of scientific art in which living bacteria are used as “paints” to create images or patterns on a nutrient agar plate. The bacteria grow and multiply, producing different colors and textures depending on their species and pigments.
It combines microbiology and creativity, showing both the beauty of microorganisms and their diversity.
Example:
Different bacterial species like Serratia marcescens (red), Micrococcus luteus (yellow), and Pseudomonas aeruginosa (green) can be streaked or spread on agar plates to form colorful designs.
Materials Required
| Nutrient agar (NA) plates | Laminar air flow |
| Sterile inoculating loop | Bunsen burner |
| Bacterial cultures | Incubator (30–37 °C) |
Procedure
Prepare Nutrient Agar Plates
1. First, take 50 ml of distilled water in a 250 ml conical flask.Then add 2.8 g of nutrient agar and mix well. After it is properly mixed, add distilled water up to 100 ml.
2. Autoclave at 121°C for 15 – 20 min.
3. Then after autoclaving, the nutrient agar media and petri plate are bought into laminar airflow.
4. Pour the sterile nutrient agar media into petri plate and allow it to solidify.


5. Selection of different colour Bacteria
A. White / Cream colonies
Source : Milk, yogurt, skin.
B. Pink / Orange Yeast
Source: Refrigerator walls, wet kitchen areas
C. Red / Pink Bacteria
Source : bathroom tiles, sink corners, water-tap
D. Yellow Bacteria
Source : soil sample
6. After the nutrient agar solidifies in the Petri plate, inoculate the collected bacteria on the plate using a sterile wire loop.
7. Packed petri plates with parafilm. And kept it in incubator at 37 C temp for 4 – 5 days.
Procedure
- Prepare Agar Plates:
• Pour warm, sterile nutrient agar into Petri dishes (about 15–20 mL each).
• Let them cool and solidify completely. - Plan Your Design:
• Draw your design or text on paper first to guide your art.
• Choose 1–2 types of bacteria with different colors for contrast. - Inoculation (Drawing with Bacteria):
• Work near a flame or in a clean area.
• Dip a sterile cotton swab or loop into the bacterial culture.
• Gently “draw” or “write” on the agar surface according to your design.
• Do not press too hard—just touch the surface lightly. - Label and Incubate:
• Close the lid and tape the plate edges.
• Label with your name, date, and type of bacteria used.
• Place the plate upside down in an incubator at 30–37°C for 24–48 hours. - Observe the Result:
• After incubation, observe the design formed by bacterial colonies.
• Different bacteria will produce different colors and textures.
• Record your observations and take a photo of your bacterial art.
Safety Precautions
• Always wear gloves and avoid touching bacterial cultures directly.
• Keep food and drinks away from the lab.
• Dispose of used plates by soaking them in disinfectant (bleach) before throwing away.
• Wash hands thoroughly after the activity.
• Use only safe, non-pathogenic bacterial strains approved by your teacher.